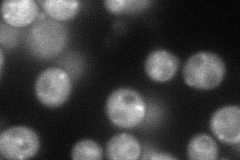
YDR202C
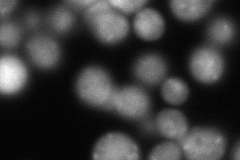
YDR202C
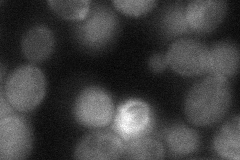
YDR202C
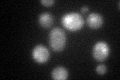
YDR202C

View description
Subunit of RAVE (Rav1p, Rav2p, Skp1p), a complex that associates with the V1 domain of the vacuolar membrane (H+)-ATPase (V-ATPase) and promotes assembly and reassembly of the holoenzyme
Localization:
Intensity:
Fold change:
Significance:
-
C’ GFP library in SD

vacuole23.18 -
N' NOP1pr-GFP in SD
cytosol,punctate76.659 -
N' TEF2pr-mCherry in SD
punctate,vacuole membrane110.429 -
N' NATIVEpr-GFP in SD

below threshold28.6943 -
N' TEF2pr-VC and Cyto-VN in SD
cytosol42.4181 -
C’ GFP library in SD+DTT
vacuole26.751.15No -
C’ GFP library in SD+H2O2

vacuole25.261.08No -
C’ GFP library in Starvation Media

vacuole44.741.92Yes -
C’ GFP library on the background of Pup2-DaMP

vacuole -
C’ GFP library on the background of CCT mutant

vacuole18.1990.78489No
